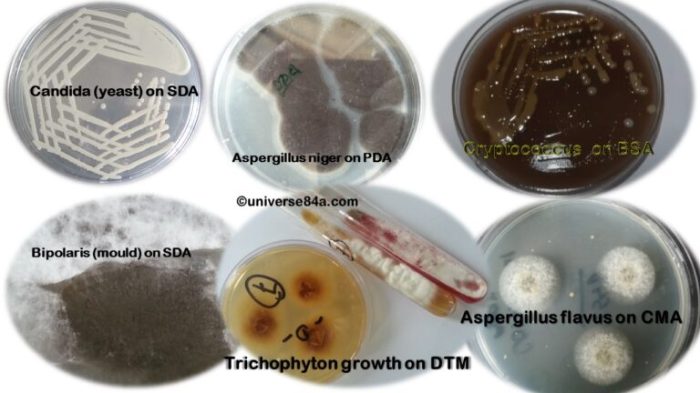
Taxidermy for Mycology: 11 Fungi Preservation Methods
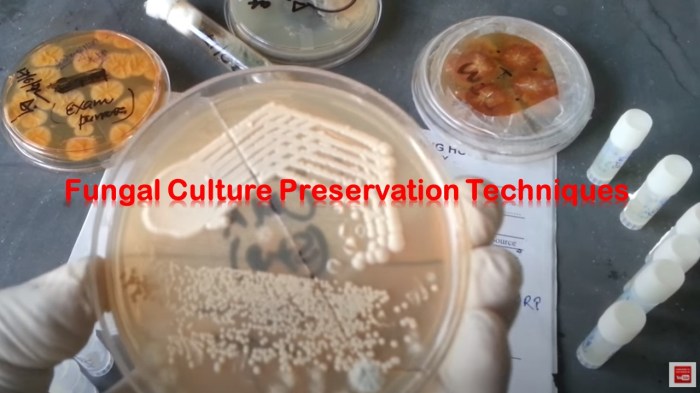
Fungi vintage identification collective anatomical decorative models saved

Preserving fungi, a captivating realm within mycology, extends beyond simple specimen collection. Taxidermy for fungi offers a unique avenue for showcasing the intricate beauty and diversity of these organisms. This exploration delves into eleven distinct preservation methods, guiding you through the selection, preparation, and artistic display of fungal specimens. From the meticulous cleaning of delicate mushrooms to the careful application of resins, we will unravel the techniques needed to create lasting tributes to the fungal kingdom.
This guide covers everything from choosing the right specimens and employing various preservation techniques like air drying and resin casting, to creating visually stunning displays that highlight the unique characteristics of each fungus. We’ll explore the use of different materials and methods, offering a comprehensive overview for both beginners and experienced mycologists interested in elevating their fungal preservation skills.
Fungal Specimen Selection and Preparation
Selecting and preparing fungal specimens for taxidermy requires careful consideration of the species, its condition, and the preservation methods to be employed. The goal is to create a visually appealing and scientifically accurate representation of the fungus, maintaining its structural integrity and color as much as possible. Proper preparation significantly impacts the longevity and aesthetic quality of the final display.
Successful fungal taxidermy relies heavily on selecting specimens in optimal condition. Ideal candidates are firm, undamaged, and relatively free from insect infestation or decay. The size of the fungus should be appropriate for your display goals; smaller specimens may be easier to manage, while larger ones offer more impressive visual impact. Species with unique features, vibrant colors, or interesting shapes are particularly well-suited for showcasing the diversity of the fungal kingdom. Avoid specimens that are already showing signs of significant decay, as these will be difficult to preserve effectively.
Specimen Cleaning and Stabilization
Cleaning a fungal specimen is the crucial first step. Gentle brushing with a soft brush can remove loose debris such as dirt, leaves, or insects. For more stubborn material, a soft-bristled toothbrush and distilled water may be used cautiously, ensuring the fungus isn’t over-saturated. Fragile structures should be supported during cleaning to prevent damage. After cleaning, allow the specimen to air dry completely in a cool, shaded area. This drying process is essential to prevent mold growth during the preservation process. Stabilizing fragile structures often involves carefully inserting thin wires or supports into the specimen to maintain its shape during the drying process. This is particularly important for specimens with delicate caps or stems.
Preparing Different Fungi Types for Taxidermy
Different fungal types require slightly different approaches to preparation. Mushrooms, for example, benefit from careful cleaning of their gills and stems. Bracket fungi, due to their often woody nature, may require more robust support during the drying process. Lichens, due to their composite nature, require a delicate touch to prevent damage to the fungal and algal components.
| Fungi Type | Cleaning Method | Stabilization Technique | Special Considerations |
|---|---|---|---|
| Mushrooms (Agaricus spp.) | Gentle brushing with soft brush; distilled water for stubborn debris. | Wire supports for cap and stem, particularly if fragile. | Avoid over-wetting, which can damage the gills. |
| Bracket Fungi (Ganoderma spp.) | Brush off loose debris; careful removal of any adhering substrate. | Internal wire supports for large specimens to prevent warping during drying. | Consider using a sealant to protect against cracking due to desiccation. |
| Lichens (various spp.) | Gentle brushing with very soft brush; avoid using water. | Minimal intervention; use of small pins or supports only if absolutely necessary. | Handle with extreme care due to the delicate nature of the thallus. |
Preservation Techniques

Preserving fungi for study or display requires careful consideration of the chosen method, as different techniques are suited to various fungal types and intended uses. The longevity and aesthetic quality of the preserved specimen are heavily dependent on the chosen preservation method and the meticulousness of its application. This section details several common preservation techniques, highlighting their strengths and weaknesses.
Comparison of Fungal Preservation Methods
Five common methods for preserving fungi are air drying, freeze-drying, liquid preservation in alcohol, resin casting, and silica gel desiccation. Each offers unique advantages and disadvantages. The optimal choice depends on factors such as the type of fungus, the desired outcome (research, display, etc.), and available resources.
- Air Drying: This traditional method involves slowly drying the fungus in a well-ventilated area, ideally with low humidity. Advantages include simplicity and low cost. Disadvantages include the potential for shrinkage, distortion, and insect infestation. It is best suited for robust specimens like larger mushrooms.
- Freeze-Drying: This method involves freezing the fungus and then removing the water through sublimation. Advantages include minimal shrinkage and distortion, preserving the original structure and color well. Disadvantages include high cost and the need for specialized equipment. It’s ideal for delicate specimens and long-term preservation.
- Liquid Preservation in Alcohol: Immersion in ethanol (typically 70-95%) prevents decomposition. Advantages include effective preservation and ease of storage. Disadvantages include potential color alteration and the need for proper handling to avoid damage to the specimen. This is suitable for smaller fungi or specimens requiring detailed microscopic examination.
- Resin Casting: Embedding the fungus in a clear resin creates a three-dimensional, long-lasting display. Advantages include excellent preservation and aesthetic appeal. Disadvantages include potential for air bubbles and the need for specialized materials and skills. This is well-suited for creating attractive displays.
- Silica Gel Desiccation: This method uses silica gel to rapidly absorb moisture. Advantages include rapid drying and minimal shrinkage. Disadvantages include the cost of silica gel and the potential for damage to delicate structures if not handled carefully. It’s useful for preserving delicate specimens and speeding up the drying process.
Materials Used in Fungal Preservation
The success of fungal preservation relies heavily on the appropriate selection and use of materials. Drying agents like silica gel rapidly remove moisture, preventing decay. Resins offer long-term protection and aesthetic appeal. Properly designed display cases protect the preserved specimens from environmental damage and pests.
Resin Properties and Suitability for Fungi
The choice of resin is crucial for creating durable and visually appealing specimens. Different resins possess unique properties influencing their suitability for various fungi.
| Resin Type | Properties | Suitability for Fungi |
|---|---|---|
| Epoxy Resin | High clarity, strong, durable, UV resistant | Suitable for most fungi, especially those requiring long-term preservation and aesthetic appeal. |
| Polyester Resin | Less expensive than epoxy, good clarity, less durable | Suitable for less demanding applications, where high durability isn’t paramount. |
| Acrylic Resin | Good clarity, relatively easy to work with, less durable than epoxy | Suitable for smaller specimens or temporary displays. |
Air Drying a Mushroom Specimen: A Detailed Diagram
A properly labeled diagram would show a mature, cleaned mushroom specimen placed cap-down on a screen or wire mesh rack inside a well-ventilated, shaded area with low humidity (ideally below 50%). The air circulation should be gentle to avoid damage to delicate structures. The process would be illustrated over a period of several days to weeks, showing the gradual reduction in moisture content and the final dried specimen. Labels would indicate the environmental conditions (temperature and humidity), drying duration, and the importance of regular monitoring for signs of mold or insect infestation. The final illustration would show the fully dried mushroom, appropriately labeled with scientific name, collection date, and location. The diagram would also emphasize the importance of proper storage in a cool, dry, and insect-proof environment after drying. This slow drying process typically takes several days to several weeks depending on the size and type of mushroom and environmental conditions.
Display and Presentation of Preserved Fungi
Preserving fungi is only half the battle; showcasing their unique beauty and scientific value requires careful consideration of display and presentation methods. Effective display not only enhances the aesthetic appeal but also facilitates educational purposes and scientific study. A well-presented specimen can inspire awe and curiosity, leading to a deeper appreciation for the diversity and importance of fungi in our ecosystems.
The successful display of preserved fungi hinges on a balance between artistic creativity and scientific accuracy. The chosen method should highlight the specimen’s key characteristics while maintaining its integrity and preventing deterioration. Various techniques, ranging from traditional methods to innovative approaches, can be employed to achieve this goal.
Creative Display Methods for Preserved Fungi
Several creative display methods exist for showcasing preserved fungi, offering a blend of traditional and modern approaches. These techniques cater to different preferences and contexts, ranging from simple, elegant presentations to more elaborate and artistic installations.
- Traditional Herbarium Mounting: This classic method involves carefully adhering the dried specimen to archival-quality paper or card, providing a clean and informative presentation. The specimen is often accompanied by detailed labels specifying the species, location, and collection date.
- Shadow Boxes: Shadow boxes offer a three-dimensional presentation, allowing for the inclusion of additional elements such as background materials or accompanying plants to create a more immersive display. The specimen can be mounted on a small stand within the box, highlighting its texture and form.
- Resin Encapsulation: Encasing specimens in clear resin creates a visually striking, long-lasting display. This method protects the fungus from environmental damage while allowing for 360-degree viewing. Different resin types offer varying degrees of clarity and hardness.
- Dioramas: Dioramas offer a compelling way to recreate a fungal ecosystem, showing the fungus in its natural habitat. These miniature scenes require careful planning and execution, but the result is a highly engaging and educational display.
- Microscopic Slides and Photographic Displays: For showcasing microscopic features or capturing the beauty of fungi at different scales, microscopic slides and high-quality photographs can be effectively incorporated into the presentation. These provide valuable insights into the specimen’s intricate structures.
Examples of Artistic Taxidermy Displays of Fungi
Artistic taxidermy displays elevate the presentation of preserved fungi beyond simple preservation, transforming them into captivating works of art. These displays often incorporate elements of sculpture, photography, and even miniature landscape design.
For instance, a preserved *Amanita muscaria* could be displayed atop a miniature, moss-covered log, creating a whimsical forest scene. The use of natural materials like moss, lichen, and small twigs adds to the realism and aesthetic appeal. Alternatively, a collection of various polypore fungi could be artistically arranged on a piece of driftwood, showcasing the diverse shapes and colors within a single genus. The incorporation of subtle lighting can enhance the display’s impact, highlighting textures and colors.
Diorama Construction for Fungal Ecosystems
Constructing a diorama involves careful planning and execution. The goal is to recreate a realistic miniature ecosystem, showcasing the fungus in its natural environment.
- Base Construction: Begin by creating a sturdy base using a shallow box or tray. This will form the foundation of the diorama.
- Terrain Creation: Use materials like plaster, clay, or modeling compound to sculpt the terrain. This could involve creating a forest floor, a decaying log, or a section of soil.
- Background Creation: A backdrop can be created using painted cardboard, fabric, or even a photograph of the natural habitat. This provides context and depth to the scene.
- Specimen Placement: Carefully place the preserved fungal specimens within the diorama. Ensure they are securely positioned and appear natural within the recreated environment.
- Adding Details: Incorporate additional elements such as miniature plants, insects, or other organisms to enhance realism. Use materials like moss, lichen, twigs, and small stones to add texture and detail.
- Finishing Touches: Once all elements are in place, consider adding subtle lighting to highlight the specimens and create a more immersive experience.
Creating Visually Appealing and Informative Display Labels
A well-designed label is crucial for providing essential information and enhancing the overall presentation. The label should be clear, concise, and aesthetically pleasing, complementing the display rather than detracting from it.
A label should include the following information:
- Scientific Name (Genus and Species): Use the correct binomial nomenclature.
- Common Name (if applicable): This provides a readily understandable name for the general public.
- Location of Collection: Include the specific geographic location where the fungus was found, with as much detail as possible (e.g., coordinates, altitude).
- Collection Date: Specify the date the specimen was collected.
- Collector’s Name: Indicate the person who collected the specimen.
- Additional Notes (optional): This could include information on substrate, habitat, or any unique characteristics.
The label should be printed on acid-free paper or card stock to ensure its longevity. The font should be legible and the information clearly organized. Consider using a visually appealing layout and design to enhance the label’s aesthetic appeal.
Closing Notes

Mastering the art of fungal taxidermy allows for the creation of captivating displays that not only preserve these fascinating organisms but also serve as educational tools and artistic expressions. By understanding the nuances of each preservation method and applying creative display techniques, one can effectively communicate the beauty and importance of the fungal world. Whether for scientific study, personal enjoyment, or artistic expression, the methods detailed here provide a framework for preserving the wonders of fungi for years to come. The careful selection of specimens, precise preservation techniques, and artistic display methods combine to create a lasting legacy of these often overlooked yet vital organisms.